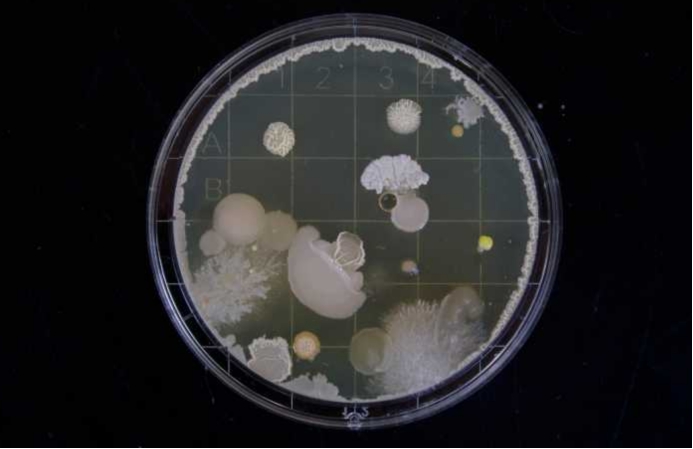
美国真菌感染传播,美国暴发超级真菌传染途径
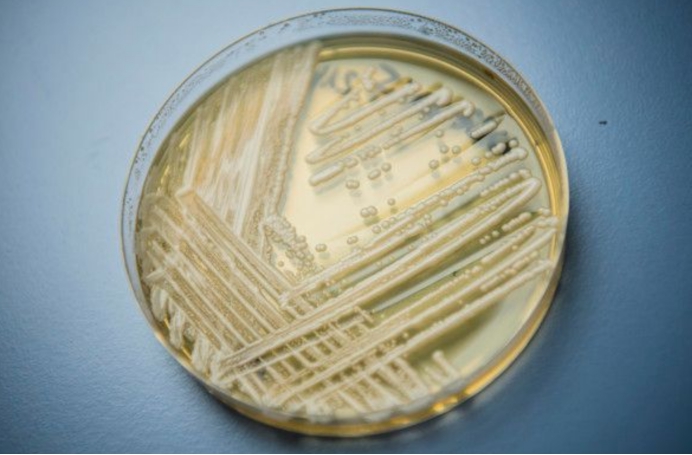
美国真菌感染传播,美国暴发超级真菌传染途径

2021年的美国,还真的是多灾多难。持续的高温天气还没有退去,西部的山火规模也越来越大,同时,疫情也没有得到控制,这些都让美国如今很糟糕,不过,似乎这些对于美国来说还不够,近日,在美国一种被专家称作“无法治愈”的超级真菌,竟然又开始悄悄传播。

美国出现“超级真菌”传播,已有3人死亡
根据报道,7月22日,美国的卫生官员表示,在美国的两家医院和一家疗养院内,都发现了一种无法治愈的超级真菌存在,目前,已经造成上百人被感染,3人死亡。
从超级真菌爆发的地点来看,这一次主要是在华盛顿特区和得州的达拉斯地区,而且从药物治疗来看,感染了这种超级真菌的患者,普遍都出现了耐药性,而且这种真菌还可以在人类之间传播,这也意味着,如果短期内无法控制,可能后续会导致更多的人感染。

说起来,这并不是美国第一次爆发超级真菌,在2019年的时候,美国也曾经爆发过超级真菌感染,而且真菌来源并不明确,短期内就让美国数百人感染,而且致死率超过了60%。
和这一次一样,2019年美国的超级真菌感染的首发地点,也是在医院,同样,患者也都表现出了极强的抗药性,并且传播速度极快。
而再早之前,美国出现这种超级真菌的传播,则是从2013年开始的,没有人知道这种真菌究竟是如何出现的,只不过,通过追溯发现,最早是在日本出现的,而出现的时间,则是在惊人的2009年。
有观点认为,这种超级真菌可能是某种进化后的产物,不过,这并不意味着它是被人工培育出来的,这一点大家不要担心,只能说自然界真的太强大了,而且真菌作为微生物的一种,本身它们也是和其它生物一样,都是不断在进化之中的,再加上人类本身对于微生物的世界,了解就没有那么多,这也没有什么好奇怪的。
这种超级真菌究竟是什么?
既然这种超级真菌早在2009年的时候,就已经出现了,为何过去的10多年时间里,科学家们仍然没有办法应对它们,解决它们感染传播的问题呢?
这种超级真菌,它的学名是“耳念珠菌”,它是一种对抗真菌药物具有极强抗药性的真菌,多年来,通过对“耳念珠菌”的研究,研究者发现它们的颜色一般为白色或者是粉色,主要对本身就患有慢性病,或者是住院治疗的病人,具有极强的感染和传播能力,甚至即使是抗生素,对它也是丝毫不起任何抵抗作用的。

除了美国,“耳念珠菌”目前已经传播到了全球12个国家,包括我国,也曾经在2019年的时候,出现了感染“耳念珠菌”的病例,只不过当时很快就得到了控制,不像美国导致了数百人感染。
同时,研究者也发现,虽然“耳念珠菌”的传播能力很强,但是,它对于健康的普通人是不起作用的,这也意味着,大家不要认为这种超级真菌在美国爆发了,而且我国也曾经出现过感染病例,就会认为它和如今的疫情一样,会导致大范围传播,这种担心是多余的。

“耳念珠菌”也可以感染动物
除了可以在人类之间造成传播之外,研究者发现,“耳念珠菌”还可以感染动物,很多哺乳动物都可以成为“耳念珠菌”的寄主,而且“耳念珠菌”也可以在自然界中独立生存。
今年3月份,本身也存在“耳念珠菌”感染病例的印度,来自德里大学的科研人员,在野外考察的时候,发现了“耳念珠菌”的存在,它们分布在沼泽、沙滩和岩石海岸之中,所以,研究者认为,这个发现也证明,“耳念珠菌”最早是来自于大自然的。
至于“耳念珠菌”究竟是如何进入人类世界的,有观点认为,这可能与全球变暖有关,在环境的变化之中,“耳念珠菌”也开始了新一轮的进化,最终让它们变得更强大,一直都2009年的时候,出现在了人类世界之中。
这一次的发现,也为研究“耳念珠菌”,提供了更多的参考数据,也可以帮助人类更好地了解它,以及想办法去对抗它带来的伤害。

同时,也可以了解到它究竟是通过什么途径,进入到人类世界之中的,要知道,在2009年日本首次发现“耳念珠菌”感染的病例之后,在溯源的过程中,就一直都没有任何的线索表明,它究竟是来自哪里。那么,在你看来,这种超级真菌,它究竟是如何进入人类世界的呢?